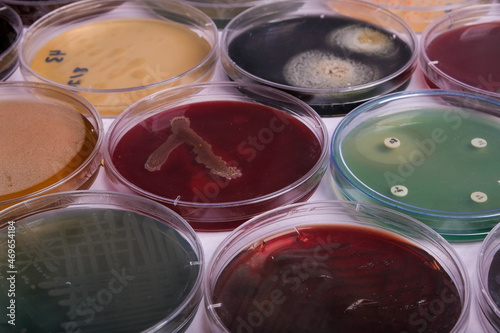
Canvas Print collection of culture plates contain growth of microorganisms on different agar

-
Brands & Merch
- Movie Posters
- Batman
- Spider-Man
- Star Wars
- Harry Potter
- MARVEL
- DISNEY
- Pokémon
- Show all
- Music Posters
- Queen
- Rolling Stones
- AC/DC
- The Beatles
- Bob Marley
- Iron Maiden
- Metallica
- Show all
- Anime & Manga
- Attack on Titan
- Pokémon
- Demon Slayer
- Jujutsu Kaisen
- Death Note
- Dragon Ball Z
- My Hero Academia
- Show all
- Comics
- Batman
- Spider-Man
- Superman
- Captain America
- Avengers
- MARVEL
- Wonder Woman
- Show all
- Gaming Posters
- Assassin's Creed
- Nintendo
- Playstation
- Online games
- Xbox
- Minecraft
- Sonic
- Show all
- Posters for Children
- Harry Potter
- Minecraft
- Lilo & Stitch
- DISNEY
- Frozen
- Mickey Mouse
- Princess
- Show all
-
Illustrations
- By Theme
- Abstract illustrations
- Black & White Tones
- Travel Posters
- Quotes and texts
- Nature touch
- Collage Art
- Line Art
- Man Cave
- Fashion
- Motifs for children
- Love & Romance
- Sports illustrations
- Magazine Cover
- Women Power
- Animals
- Daily inspiration for your home or office
- By style
- Bauhaus
- Eco style
- Retro & Vintage
- Asian Atmosphere
- Scandinavian minimalism
- Art Deco style
- Boho style
- Paris Elegance
- Tropical Paradise
- Pop Art style
- Provence style
- Harmony & Calm
- Romantic castle style
- Industrial style
-
Wall Art
- Canvas Prints
- Canvas Prints
- Split canvas prints
- Canvas Prints -60 %%
- Show all
- Wall Art
- Fine Art Prints
- Framed Posters -20 %%
- Framing: Frames and hangers
- Custom Canvas Print
- Split canvas prints
- Fine Art Prints
- Florent Bodart
- Paul Cézanne
- Claude Monet
- Pierre-Auguste Renoir
- Sam Toft
- Leonardo da Vinci
- Alphonse Mucha
- Hieronymus Bosch
- Gustav Klimt
- Wassily Kandinsky
- Leonetto Cappiello
- Vincent van Gogh
- Katsushika Hokusai
- Show all
-
Photography
- Themes
- Black & White Elegance
- Animals
- Nature & Landscape
- Trip around the world
- Proof of Love
- Everyday Life
- Macro
- Exotic adventure
- Minimalistic Beauty
- Old School
- Panoramic Posters
- Tasty World
- Mountain Vibes
- Aerial View
-
Posters
- Framing: Frames and hangers
- Stock Frames
- Poster hangers
- Accessories
- Wall Murals
- Wall Murals -60 %%
- Best Sellers
- Stickers
- 3D Wall Murals
- Patterns & Ornaments
- Movie Wall Murals
- Wall Murals By Room
- Brands & Merch
- Movie Posters
- Music Posters
- Anime & Manga
- Comics
- Gaming Posters
- Posters for Children
- Sports
- Celebrities
- Posters
- Bestsellers - TOP
- New Releases
- Print your photos
- Brands & Merch
- Last chance -60 %%
- Sales up to -80 %%
- Wall Decorations
- Framing: Frames and hangers
- Motifs
- Abstract Art
- Animals
- Architecture
- Auto - Moto - Aero
- Black & White
- Celebrities
- Cityscapes & Cities
- Educational Posters - For Schools
- Erotic Posters
- Fantasy & Mystery
- Fashion
- Fine Art Prints
- Flags
- Food & Drinks
- For Business
- Funny posters
- History & Religion
- Illustrations
- Love & Romance
- Maps
- Motivational Posters & Quotes
- Nature & Landscape
- Parties, Celebrations, Holidays
- Sports
- The Universe
- Travelling
- Wall Decorations
- Metal Signs
- Poster set
- Door Posters & Wallpapers
- Furniture stickers
- XXL Large Posters
- Panoramic Posters
- Framed Posters -20 %%
-
Wall Murals
- Wall Murals -60 %
- Best Sellers
- Stickers
-
3D Wall Murals
-
Patterns & Ornaments
-
Movie Wall Murals
- Wall murals for a teenager's room
- Wall murals for the bedroom
- Wall murals for the living room
-
Wall Murals By Room
- Show all
-
 Motifs for children
Motifs for children
 World Maps
World Maps
 Nature & Landscape
Nature & Landscape
 Wall murals for the children's room
Wall murals for the children's room
-
Mugs & Dishes
- Dishes
- Metal Tins & Lunch Boxes
- Bottles
- Bottle Openers
- Coasters
- Glasses
- Shot Glasses & Hip Flasks
- Plates & Bowls
- Teapot
- Dishes by Motifs
- Anime dishes
- Tableware Auto-Moto
- Retro Tableware
- Famous Artists Tableware
- Fantasy dishes
- Film & TV dishes
- Gaming dishes
- Dishes for children
- Music dishes
- Comics dishes
- Sports Tableware
- Funny dishes
- New Releases
-
Clothing
- Clothing
- Jumpers & Sweaters
- Caps & Hats
- Winter clothes
- Socks
- Trousers
- Nightwear & Pyjamas
- Bathrobes & Towels
- Bags & Rucksacks
- Wallet
- Jewelry & Beauty Accessories
- Umbrellas
- Gaming Sleeves
- Underwear
- New Releases
- T-Shirts & Tops
- Women's T-shirts
- Men's t-shirts
- Children's T-shirts
- T-shirts – Private Brand
- Custom Photo T-Shirt
- T-Shirts -60 %%
- T-shirts by brand
- Music T-shirts
- Anime T-shirts
- Movie & TV T-shirts
- Gaming T-shirts
- Harry Potter
- Star Wars
- The Lord of the Rings
- MARVEL
- Batman
- T-shirts by theme
- T-shirts with motifs of famous artists
- Sports-themed T-shirts
- Abstract T-shirts
- T-shirts with Asian designs
- Line art T-shirts
- Food & Drink T-shirts
- T-shirts with animals
- T-shirts Auto Moto
- Kids-themed T-shirts
- T-shirts with flags
- T-Shirts with Signs and Pictograms
- Funny T-shirts
- Quote T-shirts
- Bauhaus T-shirts
- Pop Art T-shirts
- Stand with Ukraine
-
T-Shirts & Tops
- Jumpers & Sweaters
-
Caps & Hats
-
Winter clothes
- Socks
- Trousers
- Nightwear & Pyjamas
- Bathrobes & Towels
-
Bags & Rucksacks
-
Wallet
-
Jewelry & Beauty Accessories
- Umbrellas
- Gaming Sleeves
-
Fashion by Motifs
-
Clothing for:
- Underwear
- New Releases
- Show all
-
 T-shirts – Private Brand
T-shirts – Private Brand
 Women's T-shirts
Women's T-shirts
 Men's t-shirts
Men's t-shirts
 Music T-shirts
Music T-shirts
 Movie & TV T-shirts
Movie & TV T-shirts
 Gaming T-shirts
Gaming T-shirts
-
Gifts & Games
- Gifts & Games
- Gift Vouchers
- Photo Gifts
- Toys
- Perfect gifts for
- Christmas
- Gifts for Men
- Gifts for Women
- Gifts for Children
- Gifts for couples
- Gifts for collectors
- Gifts for Pupils
- Gifts for Pets
- Merch
- Home Accessories
- Metal Signs
- Giftsets
- Small & Cheap Gifts
- Figurines
- Collectible replicas
- Toys
- Mugs & Dishes
- Calendars 2026 -60 %%
- Office & School Supplies
- Tin Retro Gifts
- Jigsaw puzzles
- Bags & Rucksacks
- Notebooks
- Painting materials
- Coming Soon
- Framed Posters -20 %%
- Toys
- Dolls
- MGA's Miniverse
- LEGO -20%%
- Plush Toys
- Action figures and toys
- Car Models
- CarTuned
- Hot Wheels
- Playing cards
- NERF
- Board Games
- Picture cubes
-
For Business
- For Business
- Beauty & Wellness
- Wedding Studio
- Hospitality
- Doctors
- Educational Posters - For Schools
- Fitness studio
- Street Heroes
- Office
- Experts & Businessmen
- B2B Partners
- Beauty & Wellness
- Cosmetic Studio
- Tattoo studio
- Barbershop
- Wellness & Spa
- Hair Salon & Hairdresser's
- Nail Studio
- Fitness studio
- Gym & Fitness
- Sports aesthetics
- Sports illustrations
- Automobilist
- Yoga
- Dance
- Football
- Frames & Framing
- Photo Gifts
Anaerobic - Posters, Wall Art, Canvas Prints

Contact
FAQ
About Us
Payment and Shipping
Terms and Conditions
Returns Policy
Privacy Policy
Promotions & Discounts
Loyalty Programme
Testimonials
Job Offers
Frames & Framing
Collaborate with us
For Artists
For Influencers and Affiliate
For Bands and Other Brands
For B2B partners
Tiskové služby pro firmy
Mapy
Europosters – Decorate your life
Since 1999, Europosters has been one of the top sellers of posters, wall art prints and licensed merchandise gifts in the Czech Republic and throughout Europe too. We offer a huge selection of movie, game or sports posters of all sizes as well as wide range of original gifts for true fans of Star Wars, Harry Potter, comics or the whole Warner Bros family. We know that mugs, figurines, puzzles and clothes are the best gift for everyone, regardless of age or interest. But if you are a fan of interior design, then you are in the right place too! On a daily basis we print wall murals, illustrations, photographs and art reproductions and send them to more than 25 countries to keep our customers happy.
Contact:
E-mail: info@europosters.eu
Call: +44 20 3996 3131
Monday – Friday ǀ 6:00am – 4:00pm (UK time)
© 1999–2025 Europosters. All rights reserved.




























































